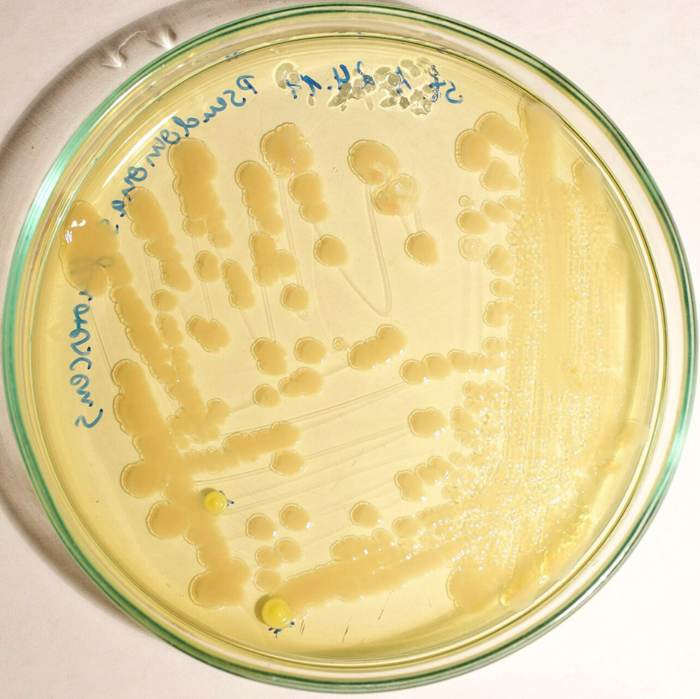

5분 읽기
- 45개의 냉장고 선반에서 면봉으로 샘플 채취, 냉장고 사용 습관과 청소 방법 설문 조사
- 냉장고에서 총 2,184종의 미생물 발견, 음식, 손, 표면 접촉으로 새로운 미생물 유입
- 대부분 박테리아는 무해,일부 병원균, 내성균도 발견
- 연구 결과는 가정용 냉장고와 같은 차가운 환경조차도 다제내성균의 저장소이자 발생원이 될 수 있음을 보여줘
냉장고 속 생명체의 향연
검사 결과, 병원균과 내성균을 포함한 수천 종의 박테리아가 발견되었다.
우리들의 냉장고는 미생물이 번성하는 생태계의 보고다. 분석 결과, 치즈, 햄, 야채 칸 등에서 수천 종의 박테리아가 서식하고 있는 것으로 나타났다. 대부분 박테리아는 무해하며 우리 피부나 음식에서 유래한다. 하지만 검사 결과, 일부 병원균과 내성균도 발견되었다고 연구팀은 밝혔다. 미생물 수를 줄이는 간단한 방법이 있다. 냉장고에만 그런 게 아니다. 가정 내 많은 식기, 가전제품, 가구에도 미생물이 풍부하게 서식하고 있다. 설거지용 스펀지와 키친타월, 먼지, 전자레인지와 세탁기 등 박테리아는 어디에나 존재한다.
 |
| ▲ 우리 냉장고에는 미생물이 득실거린다. © W.carter/ CC-by-sa 4.0 |
45대의 개인 냉장고 검사 결과
냉장고는 어떨까? 일반적으로 냉장고는 차가운 온도가 미생물의 성장을 늦추고 번식을 억제하기 때문에 미생물 침입에 대한 방어벽으로 여겨진다. 냉장고에 음식을 보관하면 더 오래 신선하게 유지된다고 생각하는 이유가 바로 이것이다. 하지만 많은 박테리아는 저온에서도 생존하며, 차가운 환경에서도 분해 활동을 계속할 수 있다.
비엔나 수의과대학의 모리츠 하르트만(Moritz Kartmann) 교수와 그의 동료들은 일반 가정집 냉장고에 어떤 박테리아가 서식하는지 자세히 조사했다. 이를 위해 연구팀은 45개의 냉장고 선반에서 면봉으로 샘플을 채취하고, 냉장고 사용 습관과 청소 방법에 대해 집주인들을 대상으로 설문 조사를 실시했다. 채취한 샘플은 고해상도 유전자 염기서열 분석을 통해 냉장고에 존재하는 미생물의 종류와 양을 분석했다.
음식과 우리 피부에서 온 미생물
분석 결과, 냉장고는 미생물이 없는 공간이 아니라 오히려 정반대였다. 섭씨 4~5도까지 냉각된 냉장고 안에서도 수백 종에 달하는 다양한 박테리아 군집이 번성하고 있었다. 하르트만 교수 연구팀은 샘플로 채취한 냉장고에서 총 2,184종의 미생물을 발견했다. 개별 냉장고에서 발견된 미생물의 종 수는 한 가정의 26종에서 다른 가정의 589종에 이르기까지 매우 다양했다.
냉장고에 서식하는 미생물 대부분은 무해하다. 이러한 박테리아는 치즈, 사워크라우트, 김치, 특정 소시지와 같이 냉장고에 보관된 발효 식품에서 유래하는 경우가 많다. 아시네토박터(Acinetobacter)나 슈도모나스(Pseudomonas)와 같은 박테리아는 우리 피부에 흔히 서식하는 종이다. 연구진은 이러한 미생물이 손을 통해 냉장고로 옮겨진다고 설명했다. 또한, 저온에 적응한 사이크로박터(Psychrobacter)와 같은 속의 박테리아도 냉장고에서 자주 검출되었다.
정밀한 종 식별 결과, 이러한 주요 박테리아 속의 여러 종이 공존하는 것으로 나타났다. 연구팀은 이러한 현상이 전반적으로 높은 생물 다양성을 초래하며, 음식, 손, 표면 접촉을 통해 새로운 미생물이 끊임없이 유입되고 있음을 시사한다고 설명했다.
|
| ▲ 식품 변질의 원인이 되는 슈도모나스 플루오레센스(Pseudomonas fluorescens) 박테리아의 군집. © A doubt/ CC-by-sa 4.0 |
하지만 병원균도 발견돼그러나 샘플에서는 병원균도 검출되었다. 하르트만(Hartmann) 연구팀은 "샘플링한 냉장고 45대 중 27대에서 병원균으로 분류되는 종이 하나 이상 검출되었다"고 보고했다. "가장 흔하게 발견된 균은 바실러스 세레우스(Bacillus cereus)로, 23개 샘플에서 검출되었으며, 일부 샘플에서는 전체 미생물의 5.7%를 차지하는 것으로 나타났다." 이 박테리아는 빠르게 증식할 경우 식중독을 유발할 수 있다.
대부분 사람에게는 무해하지만, 면역력이 약한 사람에게는 피부 습진, 폐렴, 심지어 심각한 패혈증을 일으킬 수 있는 황색포도상구균(Staphylococcus aureus)은 7개 샘플에서 발견되었다. 연구진은 리스테리아균(Listeria)을 비롯한 다른 병원균은 각각 냉장고 샘플 하나에서만 발견되었다고 밝혔다. 하지만 연구팀에 따르면 이러한 결과는 냉장고조차 병원균으로부터 완전히 안전한 공간이 아니라는 것을 보여준다.
항생제 내성균분석 결과에서 또 다른 우려스러운 점은 많은 냉장고에서 적어도 한 가지 항생제에 내성을 가진 박테리아가 발견되었다는 것이다. 샘플에서 수십 가지의 다양한 내성 유전자가 발견되어 이를 뒷받침한다. 이러한 내성으로 인해 박테리아는 테트라사이클린, 베타락탐, 아미노글리코사이드와 같은 일반적인 항생제 계열에 내성을 갖게 된다. 베타락탐 계열에는 페니실린과 같은 광범위 항생제가 포함된다. 테트라사이클린계 항생제 또한 흔히 사용되는 광범위 항생제다.
연구진은 "이번 연구 결과는 가정용 냉장고와 같은 차가운 환경조차도 다제내성균의 저장소이자 발생원이 될 수 있음을 보여준다"고 밝혔다. 따라서 항생제 내성은 병원균이나 임상 환경에만 국한되지 않고 가정에서도 발생할 수 있다. 흥미롭게도 오래된 냉장고에서 훨씬 더 많은 내성 유전자가 발견되었는데, 이는 장기간에 걸쳐 안정적인 생물막이 축적되었기 때문으로 추정된다.
 |
| ▲ 황색포도상구균 생물막. © CDC |
정기적인 청소가 도움다행히도, 간단한 방법, 바로 청소를 통해 냉장고의 미생물 군집을 줄일 수 있다. 연구진은 "이번 연구 결과는 정기적인 청소와 같은 간단한 조치가 미생물 안전에 상당한 영향을 미친다는 것을 시사한다"고 설명했다. 장기간 청소하지 않은 냉장고에서는 미생물 수가 현저히 높게 나타났다. 이러한 냉장고에서는 안정적인 미생물 군집이 형성되어 병원균과 항생제 내성의 온상이 될 수 있다.
하르트만과 그의 동료들은 "냉장고를 주방 조리대나 식탁의 연장선으로 생각하고 정기적으로 청소해야 한다"고 강조했다. 이는 건강을 보호할 뿐만 아니라 냉장고 안의 음식이 더 빨리 상하는 것을 막아준다. 반면, 냉장고 온도를 낮추는 것은 큰 효과가 없는 것으로 나타났다. 내부 온도가 4~5도에 불과할 때 세균 다양성은 높은 온도일 때와 거의 차이가 없었다.
따라서 단순히 차갑게 유지하는 것만으로는 안전을 보장할 수 없다. 온도 조절과 위생 관리가 함께 이루어져야 냉장고가 안전한 보호 수단이 될지, 아니면 오히려 미생물 온상이 될지가 결정된다.
참고: LWT – 식품 과학 및 기술, 2026; doi: 10.1016/j.lwt.2026.119119
출처: LWT, 비엔나 수의과대학
[더사이언스플러스=문광주 기자]
[저작권자ⓒ the SCIENCE plus. 무단전재-재배포 금지]